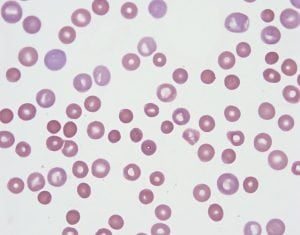
Zespół TAR (Zespół małopłytkowości)

Zespół TAR zwany potocznie promień małopłytkowości występujący jako zespół (TAR). Cechą charakterystyczną jest brak kości zwanego promień w przedramieniu. Osoby z Zespołem TAR dotknięte są niedoborem komórek krwi biorących udział w krzepnięciu. Ten niedobór płytek krwi (trombocytopenia) pojawia się zazwyczaj w okresie niemowlęcym i staje się mniej nasilone w czasie.
Syndrom TAR jest rzadkim zaburzeniem, występującym mniej niż u 1 na 100 tysięcy noworodków.
Syndrom TAR to choroba dziedziczna w sposób autosomalny recesywny. Oznacza to, że obie kopie genu są zmieniane. Dziedziczenie zmutowanego genu RBM8A następuje zazwyczaj genu od jednego z rodziców. Delecja występuje podczas tworzenia komórek rozrodczych (jaj i spermy) lub na wczesnym etapie rozwoju płodu. Chociaż rodzice osoby z zespołem TAR mogą przenosić mutację genu RBM8A lub 200 kb zazwyczaj nie wykazują objawów choroby.
Chociaż rodzice osoby z zespołem TAR mogą przenosić mutację genu RBM8A lub 200 kb zazwyczaj nie wykazują objawów choroby.
Bardzo duża rolę w życiu chorych na Zespół TAR odgrywają pierwsze lata. To właśnie one decydują o tym czy w tym czasie nastąpią najniebezpieczniejsze, zagrażające życiu krwawienia do mózgu.
Co powoduje małopłytkowość?
Małopłytkowość uniemożliwia normalne krzepnięcie krwi, co powoduje łatwe powstawanie siniaków i częste krwawienia z nosa. Odnotowuje się przypadki wystąpienia sytuacji zagrażających życiu – sytuacje ciężkich krwawień (krwotoki) w mózgu i innych narządów, zwłaszcza w pierwszym roku życia. Krwotoki mogą doprowadzić do uszkodzenia mózgu i spowodować niepełnosprawność intelektualną pacjentów z Zespołem TAR. Dotknięte dzieci, które przeżyły ten okres i nie mają szkodliwych krwotoków w mózgu zwykle rozwijają się w normalny sposób.
Najczęstsze przyczyny małopłytkowości:
– niedostateczne wytwarzanie płytek krwi,
– nadmierne niszczenie płytek krwi,
– nieprawidłowa dystrybucja,
– duże rozcieńczenie po masywnych transfuzjach. Małopłytkowości związane ze zmniejszonym wytwarzaniem płytek krwi bywają wrodzone lub nabyte.
Objawy – Zespół TAR
Do głównych objawów w Zespole TAR możemy zaliczyć niewykształcenie się kości promieniowej. Z syndromem TAR związany jest niedobór wzrostu i wiele dodatkowych nieprawidłowości w układzie szkieletowym. Braki te prowadzą do upośledzenia ruchowo-sprawnościowego a niekiedy także towarzyszy im dysfunkcja umysłowa. Bardzo często odnotowuje się przypadki wystąpienia skróconej kości łokciowej lub jej całkowitego braku, niewykształcenia się. Wówczas dłonie rozpoczynają się, wprost z ramion co powoduje że całe ręce są znacznie skrócone.
Syndrom TAR jest związany z niedoborem wzrostu i dodatkowych nieprawidłowości szkieletowych, w tym niedorozwoju kości w rękach i nogach.
Osoby z Zespołem TAR mogą mieć także wady rozwojowe serca i nerek. Syndrom TAR jest związany z wykształceniem się niezwykłych cech twarzy, w tym mikrognatią dolnej szczęki, a także nisko osadzonych uszu. Około połowa osób dotkniętych ta chorobą ma alergię na mleko krowie, które mogą pogorszyć małopłytkowości.
Przyczyny – Zespół TAR
Przyczyną wystąpienia Zespołu TAR jest mutacja genu RBM8A. Gen ten zawiera w sobie wskazówkę do tego jak powinno tworzyć się białko zwane białkiem wiążącym RNA 8A. W medycynie uważa się iż białko to uczestniczy w wielu ważnych funkcjach komórkowych które dedykowane są produkcji innych białek.
U większości pacjentów dotkniętych Zespołem TAR odnotowuję się mutację w jednej kopii genu RBM8A. Znacznie mniejsza liczba osób ma mutację w obu kopiach genu RBM8A w każdej komórce.
Osoby z jedną mutacją genu RBM8A i utratą większej liczby par nukleotydów z DNA chromosomu 1 lub dwoma mutacjami genów mają zmniejszoną ilość RNA, białka wiążącego 8A. Redukcja ta może wywoływać problemy w rozwoju niektórych tkankach, ale nie wiadomo, jak to powoduje specyficzne objawy zespołu TAR. Nie odnotowano przypadków, w których delecji, która obejmuje gen RBM8A występuje na obu kopiach chromosomu 1.
Leczenie – Zespół TAR
Skuteczne leczenie musi zostać oparte na podstawie dokładnej analizie objawów oraz szeregu badań genetycznych niezbędnych do wykonania. W celu postawienia ostatecznej diagnozy lekarz prowadzący musi koniecznie ryzyko wystąpienia innych chorób genetycznych, gdyż może to mieć ogromny wpływ na dalszy skuteczny przebieg leczenia.
Jeśli u pacjenta wystąpił brak kości promieniowej wówczas gremium medyczne może zlecić wykonanie operacji mającej na celu wyprostowanie oraz naciągnięcie przedramienia oraz nadgarstka w wyniku czego pacjent będzie operował znacznie dłuższą kończyną.
W celu przeprowadzenia skutecznego leczenia Zespołu TAR koniecznej jest wykonanie:
– regularnej kontroli poziomu płytek krwi,
– splenektomia,
– unikanie urazów,
– zaprzestanie stosowania leków przeciwpłytkowych.
Splenektomia jest to zabieg polegający na usunięciu części śledziony czyli pozbyciu się miejsca zabijania płytek krwi. Skuteczność tej choroby jest jednak stosunkowo niewielka i oscyluje na poziomie 30-40%.
Bardzo ważne jest by odpowiednio dobrać do konkretnego chorego odpowiednią metodę leczenia bo tylko prawidła diagnoza daje szanse na zminimalizowanie niedogodności wywołanych chorobą Zespołu TAR.








